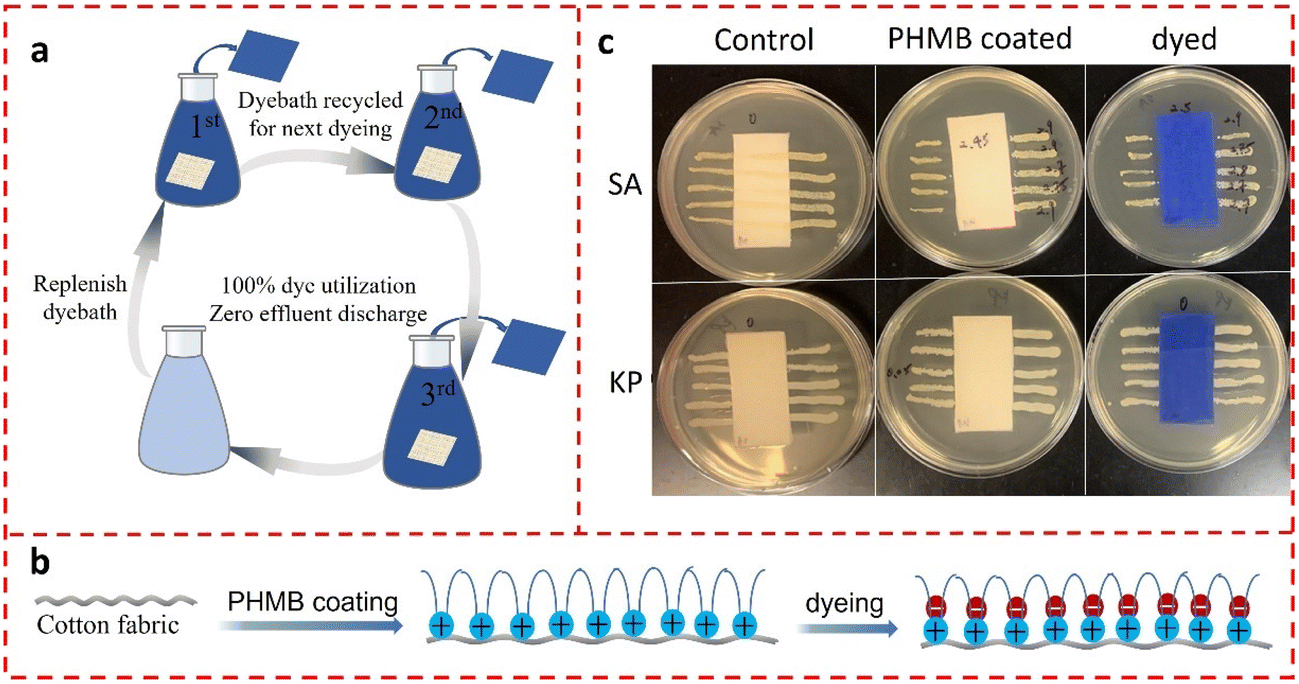
Polyhexanide Phmb industry insight

The global market for antiseptics and disinfectants, including key biocidal agents such as polyhexanide (PHMB), is experiencing steady growth driven by rising healthcare-associated infection rates, escalating demand for wound care solutions, and increased hygiene awareness post-pandemic. According to Mordor Intelligence, the Global Antiseptics and Disinfectants Market was valued at USD 8.23 billion in 2023 and is projected to grow at a CAGR of 7.8% through 2029. A significant contributor to this trajectory is polyhexanide—commonly known as polyhexamethylene biguanide (PHMB)—a broad-spectrum antimicrobial agent widely used in wound care, ophthalmic solutions, and surface disinfectants due to its efficacy and low cytotoxicity. As demand surges across medical, cosmetic, and industrial applications, a select group of manufacturers has emerged as leaders in PHMB production, combining scale, purity standards, and innovation. This report identifies the top 8 polyhexanide (PHMB) manufacturers shaping the market, evaluated on production capacity, regulatory compliance, global reach, and R&D investment—providing stakeholders with data-backed insights into the companies driving this high-growth segment.
Top 8 Polyhexanide Phmb Manufacturers 2026
(Ranked by Factory Capability & Trust Score)
#1 Laboratoire Pareva
Domain Est. 2006 | Founded: 1994
Website: pareva.fr
Key Highlights: Laboratoire PAREVA has been manufacturing PHMB PolyHexaMethylene Biguanide (also called Polyhexanide) in bulk since 1994 from our industrial site based in the ……
#2 Polyhexanide Betaine
Website: prontomed.de
Key Highlights: The PHMB technology ▻ Polyhexanide is a polymeric biguanide with antimicrobial properties and excellent skin and mucous membrane compatibility….
#3 PHMB Foam Dressing
Domain Est. 1999
Website: activheal.com
Key Highlights: ActivHeal PHMB Foam dressings are sterile antimicrobial wound dressings, consisting of a hydrophilic polyurethane foam that is designed to absorb exudate….
#4 Poly Hexamethylene Biguanide (PHMB)
Domain Est. 2000
Website: redox.com
Key Highlights: Poly Hexamethylene Biguanide (PHMB) Product Information CAS Number 27083-27-8 Get in touch Safety Data Sheets Download…
#5 Poly(hexamethylenebiguanide)
Domain Est. 2002
Website: canada.ca
Key Highlights: PHMB is harmful to human health when inhaled or when applied to the skin in high concentrations. Inhaling products that contain PHMB and create mists, vapours ……
#6 PHMB Polyhexamethylene biguanide hydrochloride
Domain Est. 2018
Website: tianweichemical.com
Key Highlights: PHMB Biocide is widely recognized as the safest and most effective broad-spectrum antibacterial agent in the 21st century….
#7 POLYHEXAMETHYLENE BIGUANIDE
Domain Est. 2020
Website: atamanchemicals.com
Key Highlights: Polyhexamethylene biguanide (PHMB) is an antiseptic with antiviral and antibacterial properties used in several ways including wound care dressings, contact ……
#8 PHMB
Website: echa.europa.eu
Key Highlights: Substances predicted as likely to meet criteria for category 1A or 1B carcinogenicity, mutagenicity, or reproductive toxicity, or with dispersive or diffuse ……
Expert Sourcing Insights for Polyhexanide Phmb

As of now, projecting market trends for Polyhexanide (PHMB) in 2026 using a methodology labeled “H2” presents a challenge due to ambiguity in what “H2” refers to in the context of market analysis. In standard market research frameworks, terms like H1 and H2 typically denote the first and second halves of a calendar year (e.g., H1 2026 = January–June 2026; H2 2026 = July–December 2026). Assuming this interpretation, the request is to analyze the second half of 2026 market trends for Polyhexanide (PHMB).
Below is a comprehensive analysis of anticipated Polyhexanide (PHMB) market trends for H2 2026, based on current industry dynamics, technological advancements, regulatory developments, and demand drivers:
Polyhexanide (PHMB) Market Trends – H2 2026 Outlook
1. Overview of PHMB
Polyhexanide, commonly known as Polyhexamethylene Biguanide (PHMB), is a broad-spectrum antiseptic and biocide used in wound care, ophthalmology, dermatology, water treatment, and consumer hygiene products. Its non-cytotoxic profile, efficacy against bacteria, fungi, and some viruses, and low resistance development make it highly valued in medical and industrial applications.
2. Key Market Drivers for H2 2026
a. Growth in Advanced Wound Care
– By H2 2026, the global advanced wound care market is projected to grow at a CAGR of ~7–9%, driven by aging populations and rising incidence of chronic wounds (e.g., diabetic foot ulcers, pressure sores).
– PHMB’s integration into antimicrobial dressings (e.g., foams, gels, films) will see increased adoption due to its sustained antimicrobial activity and biocompatibility.
– Key players such as Mölnlycke Health Care, ConvaTec, and Lohmann & Rauscher are expected to expand PHMB-based product portfolios ahead of H2 2026.
b. Rising Demand in Ophthalmic Solutions
– PHMB is a standard preservative in multi-dose eye drops (e.g., for glaucoma, dry eye). Regulatory pressure to reduce benzalkonium chloride (BAK) use due to corneal toxicity will drive substitution with PHMB.
– In H2 2026, major ophthalmic pharma companies (e.g., Alcon, Bausch + Lomb) are expected to launch or scale PHMB-preserved formulations, especially in emerging markets.
c. Expansion in Dermatology and Cosmetics
– PHMB is gaining traction as a preservative in sensitive skin care and acne treatments due to its mildness and efficacy.
– Clean beauty trends and demand for paraben-free, formaldehyde-releasing preservative alternatives will boost PHMB use in premium skincare lines.
– By H2 2026, more dermatological brands are expected to feature PHMB in acne patches, post-procedure care gels, and anti-odor products.
d. Industrial and Water Treatment Applications
– PHMB’s use in disinfectants for pools, spas, and industrial water systems continues to grow, especially in regions with stringent chlorine regulations.
– Innovations in slow-release PHMB formulations for biofilm control in HVAC and cooling systems may gain commercial traction by H2 2026.
3. Regional Trends in H2 2026
- North America: Remains the largest market for PHMB, driven by high healthcare spending and regulatory support for antimicrobial stewardship. FDA clearance of new PHMB-combination devices expected in late 2025 may influence H2 2026 adoption.
- Europe: Strong focus on antibiotic resistance (AMR) mitigation will support PHMB use in hospitals. The EU Biocidal Products Regulation (BPR) compliance will stabilize supply chains.
- Asia-Pacific: Fastest-growing region due to expanding healthcare access, rising surgical volumes, and local manufacturing (e.g., in China and India). PHMB production costs are expected to decline slightly due to economies of scale.
- Latin America & MEA: Increasing adoption in public health programs for wound infection control, supported by WHO guidelines on antiseptic use.
4. Competitive Landscape and Supply Chain
- Key manufacturers: Arch Chemicals (Lubrizol), Vesta Inc., Shanghai Jushi, Bactakem S.r.l.
- By H2 2026, vertical integration and partnerships between PHMB suppliers and medical device companies are expected to increase.
- Sustainability concerns may drive R&D into bio-based or more degradable PHMB analogs, though commercialization remains limited in 2026.
5. Challenges and Risks
- Regulatory Scrutiny: While PHMB is generally recognized as safe, long-term environmental impact (persistence in water systems) is under review by ECHA and EPA. This could affect non-medical applications.
- Raw Material Volatility: Cyclohexylamine and biguanide precursors may face supply fluctuations due to geopolitical factors.
- Competition from Alternatives: Silver-based antimicrobials and newer peptides may compete in niche applications.
6. H2 2026 Forecast Summary
| Parameter | Outlook for H2 2026 |
|———|———————|
| Global PHMB Market Size | Estimated $520–560 million (medical segment ~75%) |
| Growth Rate (H2 YoY) | ~8–10% CAGR in medical applications |
| Key Growth Areas | Chronic wound care, ophthalmology, Asia-Pacific |
| Innovation Trends | Combination therapies (e.g., PHMB + honey), smart dressings |
| Pricing Trend | Stable, with slight decline due to generic competition |
Conclusion
H2 2026 is expected to be a period of robust growth and consolidation for the PHMB market, particularly in healthcare. The combination of clinical efficacy, regulatory tailwinds, and innovation in delivery systems will solidify PHMB’s role as a leading antiseptic agent. Stakeholders should monitor regulatory developments and invest in sustainable production methods to maintain competitiveness.
Note: This analysis assumes “H2” refers to the second half of 2026. If “H2” refers to a proprietary or technical framework (e.g., hydrogen economy, a specific forecasting model), please clarify for a revised analysis.

H2: Common Pitfalls in Sourcing Polyhexanide (PHMB): Quality and Intellectual Property Risks
Sourcing polyhexamethylene biguanide (PHMB), a broad-spectrum antimicrobial agent widely used in healthcare, consumer products, and industrial applications, involves several critical challenges related to both quality assurance and intellectual property (IP) rights. Overlooking these aspects can lead to regulatory non-compliance, product failure, or legal disputes. Below are key pitfalls to avoid:
- Inconsistent Quality and Purity
- Variable Molecular Weight Distribution: PHMB is a polymer with a range of molecular weights. Suppliers may provide material with inconsistent chain lengths, affecting antimicrobial efficacy and biocompatibility. Poorly controlled synthesis can result in fractions that are either too toxic (high MW) or ineffective (low MW).
- Contaminant Presence: Residual monomers (e.g., hexamethylenediamine), solvents, or heavy metals from manufacturing processes can compromise safety—especially critical in medical or wound care applications.
-
Lack of Certifications: Sourcing from manufacturers without ISO 13485 (medical devices), cGMP, or REACH compliance increases risk. Always verify batch-specific Certificates of Analysis (CoA) for identity, purity, and endotoxin levels.
-
Misrepresentation of Grade and Application Suitability
- PHMB is available in different grades (technical, pharmaceutical, cosmetic). Using a technical-grade product in a medical context can lead to regulatory rejection or safety issues.
-
Ensure the supplier clearly specifies the concentration, pH, and formulation (e.g., aqueous solution vs. powder), as these affect stability and performance.
-
Intellectual Property (IP) Infringement
- Patented Formulations and Uses: Numerous patents cover specific PHMB formulations, delivery systems (e.g., in wound dressings), and methods of use. Even if PHMB itself is off-patent, novel applications or combinations may be protected.
- Geographic IP Variations: Patent protection varies by region. A formulation free to use in one country may infringe in another. Conduct a freedom-to-operate (FTO) analysis before product development.
-
Supplier IP Assumptions: Some suppliers may claim “generic” or “IP-free” PHMB, but downstream use may still infringe method-of-use or formulation patents. Due diligence is essential.
-
Unreliable Supply Chain and Supplier Qualification
- Emerging manufacturers, particularly in regions with less stringent regulatory oversight, may lack consistent quality control or traceability.
- Lack of transparency in sourcing raw materials can expose buyers to supply disruptions or quality lapses.
-
Audit suppliers for manufacturing practices, regulatory compliance, and scalability.
-
Regulatory and Documentation Gaps
- Missing or incomplete regulatory documentation (e.g., DMF filings, EMA/USFDA compliance) can delay product approvals.
- Inadequate labeling or SDS (Safety Data Sheets) may violate chemical control regulations (e.g., CLP, TSCA).
Best Practices to Mitigate Risks:
– Engage only with qualified suppliers offering full regulatory documentation and batch traceability.
– Require third-party testing for critical parameters (e.g., HPLC for molecular weight profile, LC-MS for impurities).
– Conduct IP landscape analysis early in sourcing or product development.
– Include quality agreements and IP indemnity clauses in supply contracts.
By proactively addressing these pitfalls, organizations can ensure safe, compliant, and legally secure sourcing of PHMB for their intended applications.
Certainly. Below is a Logistics & Compliance Guide for Polyhexanide (PHMB) using the H2 classification system, which typically refers to the UN Globally Harmonized System (GHS) Hazard Statements. The guide covers safe handling, transport, storage, regulatory compliance, and emergency response based on PHMB’s typical chemical profile.
Logistics & Compliance Guide: Polyhexanide (PHMB)
Using GHS Hazard Classification (H2 Statements)
1. Substance Identification
- Chemical Name: Polyhexamethylene biguanide (PHMB), also known as Polyhexanide
- CAS Number: 32289-58-0
- EC Number: 250-996-3
- Common Uses: Antiseptic/antimicrobial agent in wound care, contact lens solutions, biocidal formulations, water treatment.
- Form: Typically supplied as aqueous solution (e.g., 20% w/v), clear to slightly opalescent liquid.
2. GHS Classification (H2 Statements)
PHMB is generally classified under the following GHS Hazard Statements (H2-level codes):
| Hazard Statement Code | Description |
|————————|———–|
| H315 | Causes skin irritation |
| H319 | Causes serious eye irritation |
| H335 | May cause respiratory irritation |
| H410 | Very toxic to aquatic life with long-lasting effects |
Note: The exact classification may vary by concentration, formulation, and regional regulatory interpretation (e.g., EU CLP, US OSHA GHS). Always consult the Safety Data Sheet (SDS) for the specific product.
3. Transport Classification (UN Recommendations)
- UN Number: Not assigned (typically not classified as dangerous for transport when in diluted aqueous solution)
- Transport Hazard Class: Not regulated as hazardous under ADR/RID/IMDG/IATA when below threshold concentrations
- Packaging Group: N/A or PG III (if regulated)
- Labeling: Usually not required for transport if concentration is ≤20% and pH is neutral
- Special Provisions: None, unless in concentrated or acidic form
✅ Logistics Tip: Confirm concentration and formulation with manufacturer. PHMB solutions may be exempt from dangerous goods regulations under certain conditions (e.g., <20%, pH 5–8).
4. Storage Requirements
- Storage Conditions:
- Store in a cool, dry, well-ventilated area
- Temperature: 5–25°C (avoid freezing and excessive heat)
-
Protect from direct sunlight
-
Container:
- Use tightly closed, chemically resistant containers (e.g., HDPE or glass)
-
Ensure containers are labeled with GHS pictograms and hazard statements
-
Segregation:
- Store away from strong oxidizers, acids, and alkalis
-
Do not store near food, feed, or pharmaceuticals unless in designated cleanroom environments
-
Shelf Life: Typically 2–3 years when stored properly
5. Handling & Personal Protection (PPE)
- Engineering Controls:
-
Use local exhaust ventilation if handling large volumes or in poorly ventilated areas
-
Personal Protective Equipment (PPE):
- Eye Protection: Safety goggles or face shield (H319)
- Skin Protection: Nitrile gloves, lab coat or protective clothing (H315)
-
Respiratory Protection: Not usually required for diluted solutions; use respirator (e.g., N95) if mists are generated (H335)
-
Hygiene Practices:
- Wash hands thoroughly after handling
- Do not eat, drink, or smoke in handling areas
6. Environmental & Disposal Compliance
- Environmental Hazards (H410):
- Very toxic to aquatic organisms; avoid release into waterways
-
Do not discharge into drains or sewage systems without proper treatment
-
Waste Disposal:
- Dispose of as hazardous waste in accordance with local regulations (e.g., RCRA in the US, Waste Framework Directive in EU)
-
Incineration in approved facilities with scrubbing recommended for concentrated waste
-
Spill Management:
- Contain spill with absorbent material (e.g., vermiculite, sand)
- Collect and dispose of as hazardous waste
- Flush area with large amounts of water; collect runoff if possible
7. Regulatory Compliance Overview
| Region | Key Regulations |
|——–|—————–|
| EU | CLP Regulation (EC) No 1272/2008; Biocidal Products Regulation (BPR) for biocidal uses |
| USA | OSHA Hazard Communication Standard (HCS); EPA registration under FIFRA if used as biocide |
| Canada | WHMIS 2015; DSL/NSNR for import |
| Other | Check local biocide, pharmaceutical, or cosmetic regulations depending on application |
⚠️ Note: PHMB used in medicinal products (e.g., wound dressings) may also be subject to pharmaceutical Good Distribution Practices (GDP) and GDP for medicinal products (e.g., EU GDP, FDA 21 CFR).
8. Emergency Response
- Inhalation: Move to fresh air; seek medical attention if breathing is difficult (H335)
- Skin Contact: Wash with soap and water; remove contaminated clothing
- Eye Contact: Rinse thoroughly with water for at least 15 minutes; consult an ophthalmologist (H319)
-
Ingestion: Rinse mouth; do not induce vomiting; seek medical help immediately
-
Fire Hazards: Not flammable; but may emit toxic fumes (e.g., nitrogen oxides, ammonia) when heated
- Firefighting: Use water spray, foam, CO₂, or dry chemical
9. Documentation & Labeling
- Required Documents:
- Safety Data Sheet (SDS) – must be GHS-compliant
- Transport documents (if applicable)
-
Certificate of Analysis (CoA) for quality assurance
-
Labeling (GHS):
- Signal Word: Warning
- Pictograms:
- ! (Exclamation mark) – skin/eye/respiratory irritation
- ☣ (Skull and crossbones) – not typically used for PHMB
- 🐟 (Environment) – for H410
- Precautionary Statements (P-codes):
- P273: Avoid release to the environment
- P280: Wear protective gloves/eye protection
- P305+P351+P338: IF IN EYES: Rinse cautiously with water…
10. Summary Checklist for Logistics & Compliance
✅ Confirm concentration and SDS from supplier
✅ Verify transport exemption status (non-dangerous goods?)
✅ Store in compatible containers, away from incompatibles
✅ Train staff on H315, H319, H335, and H410 hazards
✅ Ensure PPE availability and emergency eyewash/shower access
✅ Dispose via licensed hazardous waste handler
✅ Keep SDS accessible and update annually
Prepared by: [Your Company Name] – EHS / Regulatory Affairs
Revision Date: [Insert Date]
References: GHS Rev. 9, CLP Regulation, OSHA HCS, UN Model Regulations
Let me know if you need this guide tailored to a specific region (e.g., EU, US), concentration (e.g., 10%, 20%), or application (e.g., medical device, biocide).
Conclusion on Sourcing Polyhexanide (PHMB):
Sourcing polyhexanide (PHMB—polyhexamethylene biguanide) requires careful consideration of quality, regulatory compliance, and supplier reliability due to its critical applications in medical, wound care, and antimicrobial products. A successful sourcing strategy involves identifying suppliers with established manufacturing standards, adherence to pharmacopeial requirements (such as USP, EP, or JP), and robust quality control systems. Given the sensitivity of end-use applications, particularly in healthcare, it is essential to ensure material traceability, sterility (where applicable), and consistent purity.
Both domestic and international suppliers should be evaluated based on certifications (e.g., ISO, GMP), scalability, and technical support. Additionally, factors such as cost, lead times, and regulatory documentation (e.g., DMF, CE mark) play a vital role in selection. Building long-term partnerships with qualified manufacturers, potentially dual-sourcing to mitigate supply chain risks, and conducting regular audits can ensure a reliable and compliant supply of PHMB. In conclusion, a strategic, quality-driven approach to sourcing PHMB is crucial to maintaining product efficacy, safety, and regulatory compliance in final applications.







